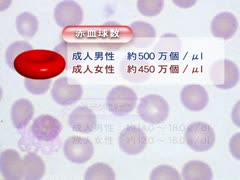

FBD-ALL
-
ポイント獲得
ISBN
[Vol.07] 運動・神経の領域
【全巻セット】病気の基礎知識 病気の成因・病態と治療DVD全10巻
通常価格
¥334,400
税込
通常価格
定価:¥352,000
セール価格
オンラインショップ価格:¥334,400
単価
あたり
配送料は購入時に計算されます。
受取状況を読み込めませんでした
DVD / ©2010年
医学、薬学、歯学、看護学をはじめ医療分野を学ぶ学生にとって、これだけは知っておきたい病気を、10の領域に各々4〜6疾患を取り上げ、8分から12分にまとめた映像データベースです。
それぞれの疾患の定義・所見・原因・分類・機序・症状・治療の概要と薬物療法について、必要な基礎を学べるようCGアニメーションを中心に病理像、実写を交えてわかりやすいムービーで解説しています。さらに「見てわかる薬の作用機序」として、治療の中心となる薬や注目されている薬の作用機序を簡潔に説明したムービーを追加しています。また、付録に三択のQ&Aを用意しています。DVDの視聴後、知識を確認してみてください。
[Vol.01] 循環の領域
[Vol.02] 血液の領域
[Vol.03] 呼吸の領域
[Vol.04] 消化の領域
[Vol.05] 代謝の領域
[Vol.06] 腎・泌尿器の領域
[Vol.07] 運動・神経の領域
[Vol.08] 精神の領域
[Vol.09] 免疫の領域
[Vol.10] 悪性新生物の領域